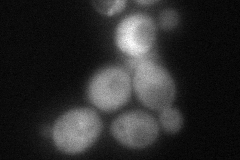
YLR150W
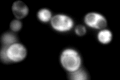
YLR150W

View description
Protein required for optimal translation under nutrient stress; perturbs association of Yef3p with ribosomes; involved in TOR signaling; binds G4 quadruplex and purine motif triplex nucleic acid; helps maintain telomere structure
Localization:
Intensity:
Fold change:
Significance:
-
C’ GFP library in SD

cytosol964.86 -
N' NOP1pr-GFP in SD

cytosol675.684 -
N' TEF2pr-mCherry in SD

cytosol605.419 -
N' NATIVEpr-GFP in SD

cytosol869.447 -
N' TEF2pr-VC and Cyto-VN in SD
cytosol84.0583 -
C’ GFP library in SD+DTT

cytosol655.830.67No -
C’ GFP library in SD+H2O2
cytosol783.950.81No -
C’ GFP library in Starvation Media

cytosol599.590.62No -
C’ GFP library on the background of Pup2-DaMP

cytosol -
C’ GFP library on the background of CCT mutant

cytosol852.320.883358No
